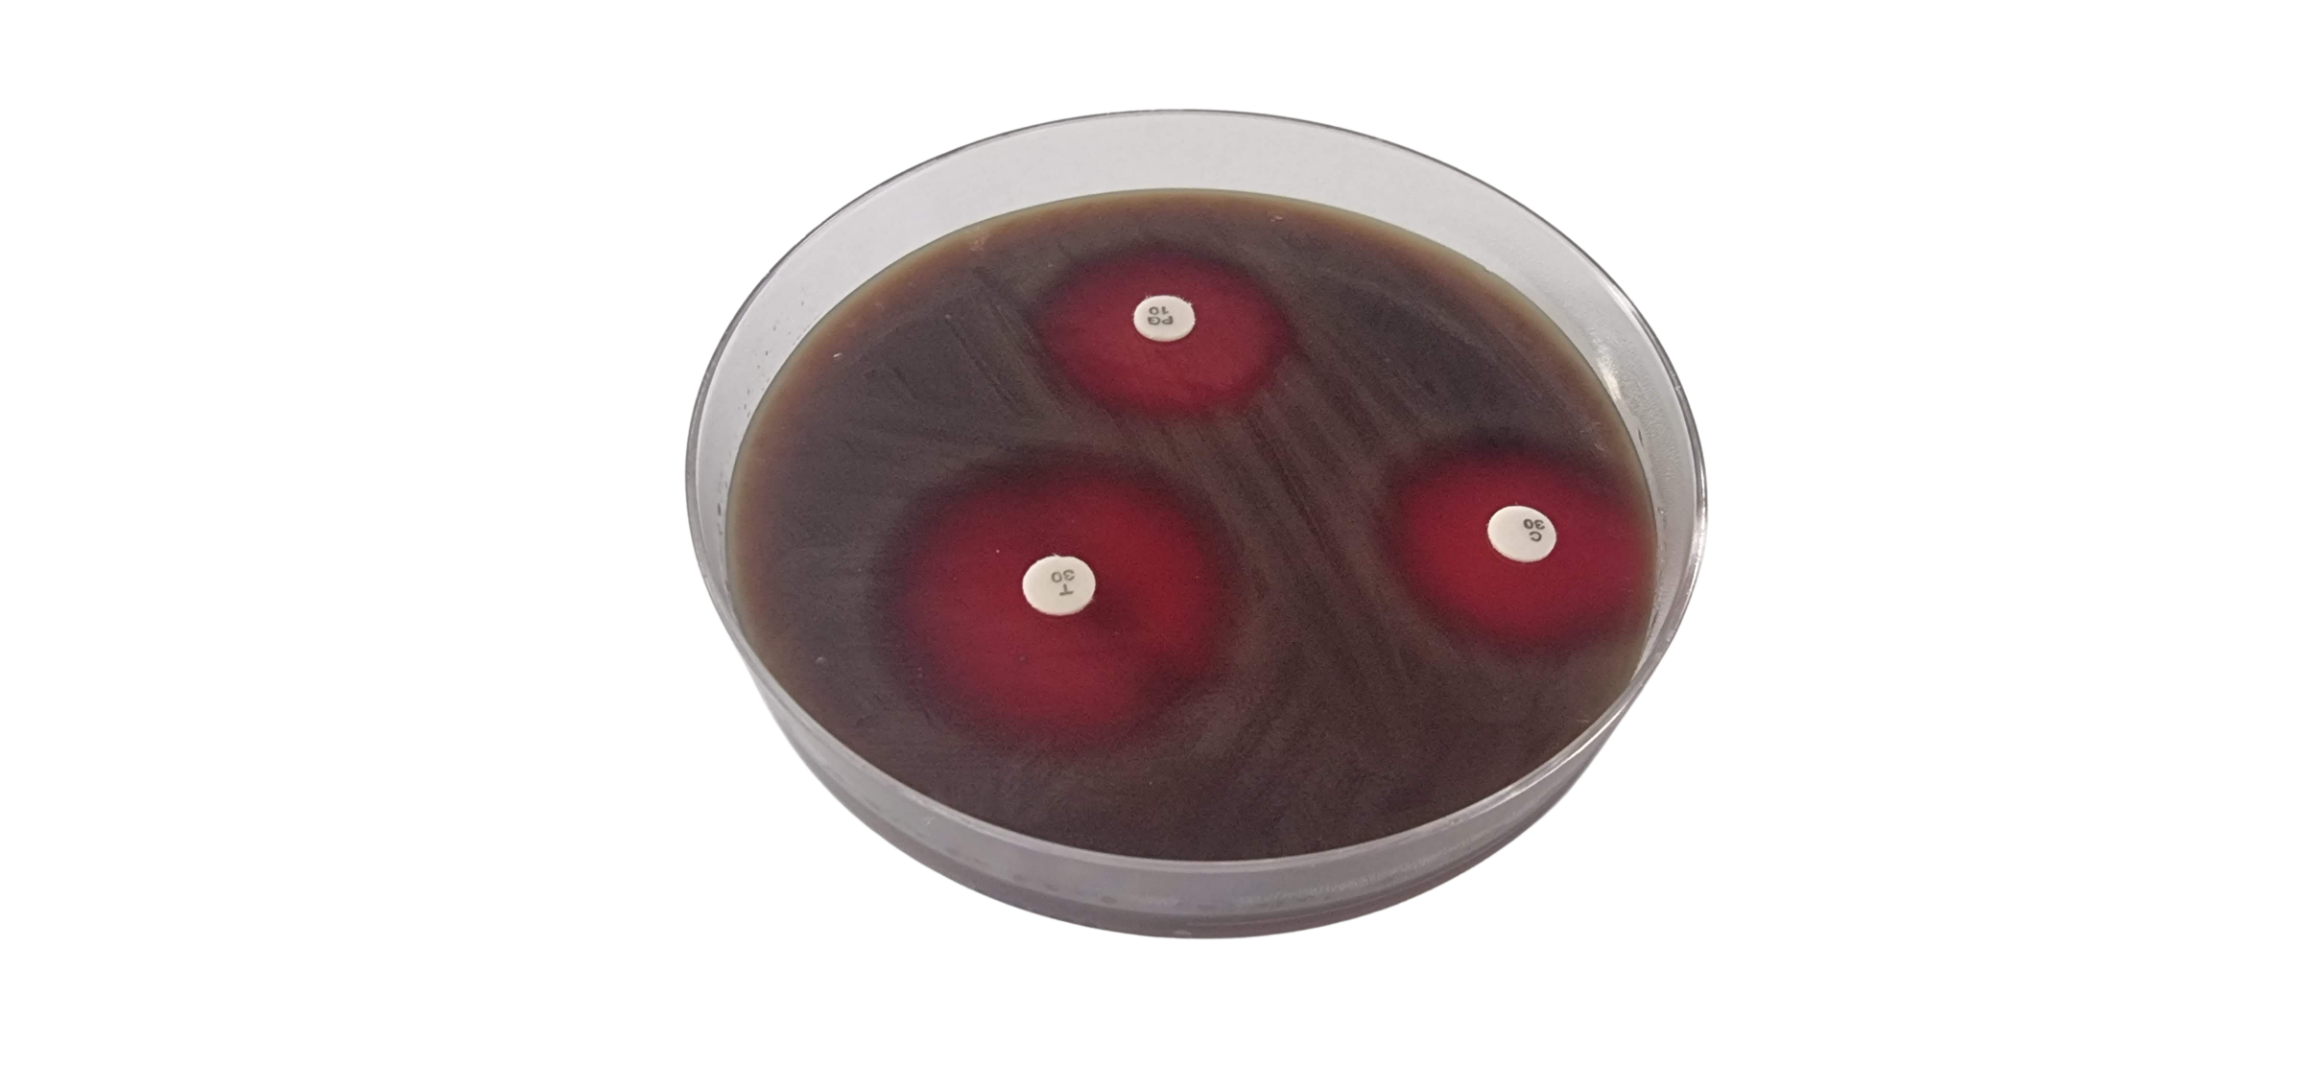

HyLabsProductsClinical DiagnosticPrepared mediaPD - Petri dishes ConventionalMueller Hinton Agar (MHA)+Def.Sheep Blood
Product: Mueller Hinton Agar (MHA)+Def.Sheep Blood
Mueller Hinton Agar (MHA)+Def.Sheep Blood
Cat No. PD037
Susceptibility testing of fastidious microorganims according to CLSI specifications